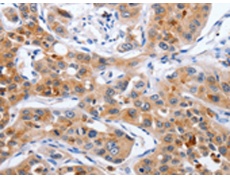
一抗

中文名稱: 兔抗NCK1多克隆抗體
英文名稱: Anti-NCK1 rabbit polyclonal antibody
別 名: NCK, nck-1, NCKalpha
抗 原: NCK1
儲(chǔ) 存: 冷凍(-20℃)
宿 主: Rabbit
相關(guān)類別: 一抗
反應(yīng)種屬: Human, Mouse
標(biāo) 記 物: Unconjugate
克隆類型: rabbit polyclonal
技術(shù)規(guī)格
|
Background: |
The protein encoded by this gene is one of the signaling and transforming proteins containing Src homology 2 and 3 (SH2 and SH3) domains. It is located in the cytoplasm and is an adaptor protein involved in transducing signals from receptor tyrosine kinases to downstream signal recipients such as RAS. Alternatively spliced transcript variants encoding different isoforms have been found. |
|
Applications: |
ELISA, WB, IHC |
|
Name of antibody: |
NCK1 |
|
Immunogen: |
Fusion protein of human NCK1 |
|
Full name: |
NCK adaptor protein 1 |
|
Synonyms: |
NCK, nck-1, NCKalpha |
|
SwissProt: |
P16333 |
|
ELISA Recommended dilution: |
1000-5000 |
|
IHC positive control: |
Human lung cancer and human colon cancer |
|
IHC Recommend dilution: |
50-200 |
|
WB Predicted band size: |
43 kDa |
|
WB Positive control: |
Jurkat and K562 cells |
|
WB Recommended dilution: |
200-1000 |


 購物車
購物車 幫助
幫助
 021-54845833/15800441009
021-54845833/15800441009